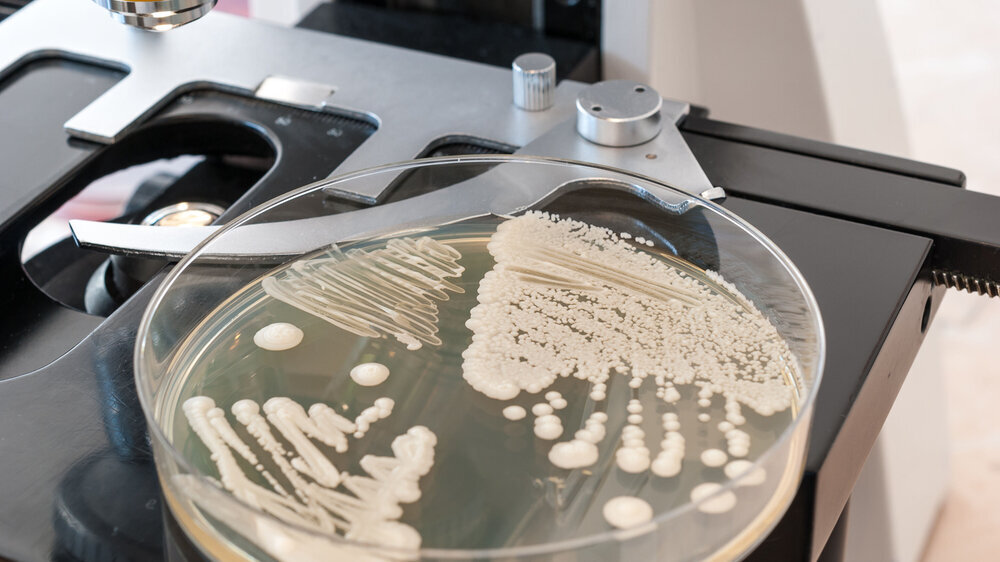

Candida albicans überlebt dank fein dosiertem Toxin
Der Hefepilz Candida albicans gehört zum Mikrobiom des Menschen und bleibt meist harmlos. Unter bestimmten Bedingungen kann er jedoch von der runden Hefeform in fadenförmige Hyphen übergehen und Infektionen auslösen – besonders gefährlich für immungeschwächte Patientinnen und Patienten. In dieser Hyphenform produziert er das Eiweiß Candidalysin, das Wirtszellen angreift.
Eine internationale Forschungsgruppe aus Zürich, Jena und Paris hat nun gezeigt: Das Pilzgift wirkt nicht nur krankmachend, sondern entscheidet auch, dass Candida albicans dauerhaft in der Mundschleimhaut überleben kann. Allerdings nur in fein abgestimmter Dosis.
Der Pilz fährt mit angezogener Handbremse
„Wir wussten, dass das Pilzgift Candidalysin Krankheiten verursachen kann. Neu ist, dass es auch nötig ist, damit der Pilz im Mund überleben kann“, berichtet Prof. Bernhard Hube vom Leibniz-Institut. „Der Hefepilz Candida albicans nutzt das Toxin wie einen Türöffner, um sich in der Schleimhaut zu verankern. Solange er es nur in kleinen Mengen bildet, bleibt er dabei unter dem Radar des Immunsystems und überlebt langfristig in der Mundhöhle."
Die Forschenden verglichen anhand eines Mausmodells zwei Stämme: Der aggressive Laborstamm SC5314 produziert große Mengen Candidalysin, was eine starke Immunantwort auslöst. Der natürliche Stamm 101 hingegen bildet nur geringe Mengen des Toxins und kann so unauffällig im Mund überleben. Eine Schlüsselrolle spielt dabei das Gen EED1, das die Hyphenbildung und damit indirekt die Toxinproduktion reguliert.
"Der Hefepilz Candida albicans nutzt das Toxin wie einen Türöffner, um sich in der Schleimhaut zu verankern.“
Bernhard Hube
„Nur wenn Candida albicans das richtige Maß findet, kann der Pilz langfristig im Mund bestehen, ohne vom Immunsystem bekämpft zu werden“, erläutert Tim Schille, einer der Studienautoren. Dieses ausbalancierte Verhalten erklärt, warum das Toxin evolutionär erhalten geblieben ist: Es sichert dem Pilz seine Nische – macht ihn aber zugleich zu einem potenziell gefährlichen Krankheitserreger.
Für die Zahnmedizin ergibt sich daraus vor allem ein besseres Verständnis oraler Candida-Besiedelungen. Therapeutische Ansätze sind aktuell noch nicht verfügbar. Bei vaginalen Infektionen konnte jedoch bereits gezeigt werden, dass sich Candidalysin neutralisieren lässt – und dadurch Gewebeschäden deutlich reduziert werden.
Frois-Martin R, Lagler J, Schille TB, et al. (2025) Dynamic Expression of the Fungal Toxin Candidalysin Governs Homeostatic Oral Colonization. Nat Microbiol, www.nature.com/articles/s41564-025-02122-4